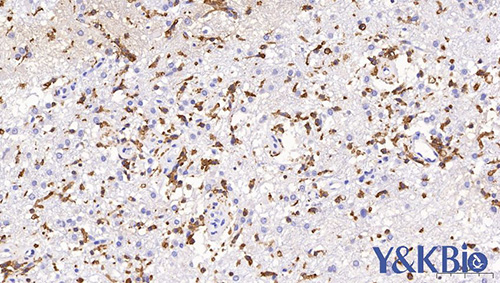

新闻动态
联系我们
陕西依科生物技术服务有限公司陕西依科生物技术服务有限公司免费为您提供{内蒙古PAS染色},{内蒙古尼氏染色},{内蒙古TRAP染色}等一些相关信息的展示发布,请您关注本站!
1.要求做冰冻切片的不一定能做内蒙古石蜡切片。因为作石蜡切片时要高温烤片,可能会破坏组织的抗原性,如果组织的抗原性较稳定,则可作石蜡切片;但是要求做石蜡切片的,可作冰冻切片。
2.冰冻切片的优点是能够较好的保存组织的抗原免疫活性,做免疫组化时不需抗原修复这一步。缺点是细胞内易形成冰晶而破坏细胞结构,可能会使抗原弥散;切片厚度较石蜡的厚,做的片子没石蜡的漂亮。当你买内蒙古一抗时,目录上都写着做什么样的切片,如果它写着只能做冰冻,就不能做石蜡,如写着两者都可,那就都能做。
3.石蜡切片的优点是可以保持组织细胞的形态结构,且容易存放在室温,而冰冻切片比较麻烦,一定要存在 -80ºC 的低温冰箱中,尤其是用来做内蒙古原位杂交的切片,为了防止 RNA 降解,保存一贯很重要。由于石蜡切片可以切到 4 μm 左右,所以原位杂交探针容易渗透到组织中去,容易成功,而且得到的颜色/形态都较冰冻切片好。
{陕西依科生物技术服务有限公司}口碑怎么样?{内蒙古PAS染色}哪里好?{内蒙古尼氏染色}找哪家?陕西依科生物技术服务有限公司专业从事{生物科研试剂的研发、销售及相关技术服务}